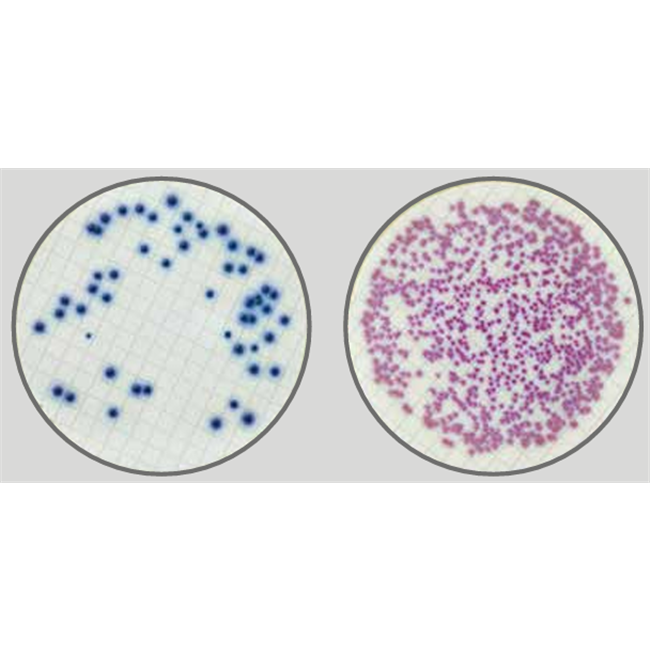

Easy DryTM are absorbent pads saturated with a sterile, dehydrated culture medium. Each pad is pre-plated in a Petri dish and is immediately ready to use after pouring sterile distilled or deionized water on it. Easy DryTM are optimal for the examination of large sample volumes by the membrane filter method.
Easy DryTM Chromatic Coliform ISO is a selective and differential chromogenic medium used for the detection and enumeration of Escherichia coli and coliform bacteria in water.
This medium complies
with ISO 9308-1:2014 for the examination of water samples with low bacterial background
flora.
PREPARATION
1.
Cut open a bag and remove the number of Easy Dry plates needed.
2.
Moisten the pad contained
in the Petri dish with 2.2 ml of sterile distilled or deionized water.
3.
Wait 5 minutes before
using.
TEST PROCEDURE
Filter the sample through a filter membrane
(0.45 µm pore diameter). Transfer
the membrane onto a plate containing a just
rehydrated pad. Incubate aerobically at 36 ± 2°C for 18-24 hours.
INTERPRETING RESULTS
After
incubation observe the color of the
colonies and interpret the results as
indicated in the ID table.
ID Table.
|
Microorganism |
Typical colony color |
|
β-D-galactosidase- and β-glucuronidase-positive E. coli* |
Dark-blue to violet |
|
Other coliform bacteria** |
Pink to red |
|
Other bacteria (if not inhibited) |
Colorless |
*β-glucuronidase-negative E. coli strains, such as E. coli O157, are pink to red on this medium.
A few strains of Shigella and Salmonella which produce the enzyme β-glucuronidase can grow as light blue colonies.
**Carry out an oxidase test (ref. 88029) to
confirm coliform bacteria which are oxidase-negative.
APPEARANCE OF THE MEDIUM
Whitish pad. Yellowish once rehydrated.
STORAGE
Store at 10-25°C away from light. Do not
use the product beyond its expiry date on the label or if product shows any
evidence of contamination or any sign of deterioration.
SHELF LIFE
2 years.